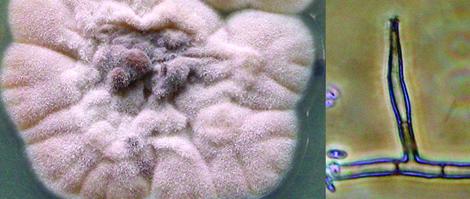
Phaeoacremonium parasiticum

Phaeoacremonium parasiticum
Synonymy:
Phialophora parasiticum
The genus Phaeoacremonium initially accommodated isolates with features similar to those seen in both Acremonium and Phialophora.
It differs from the former by having pigmented hyphae and conidiophores and from the latter by having indistinct collarettes and warty conidiogenous cells (Revankar and Sutton, 2010).
Phaeoacremonium parasiticum colony and a phialide with a small, funnel-shaped collarette.
Phaeoacremonium currently consists of 46 species with P. parasiticum and P. krajdenii recognised as the predominant species associated with human infections (Mostert et al. 2005). Other species have also been isolated from clinical cases i.e. P. alvesii, P. amstelodamense, P. griseorubrum, P. minimum, P. rubrigenum, P. tardicrescens, and P. venezuelense. Infections caused by P. parasiticum include subcutaneous abscesses, thorn-induced arthritis, and disseminated infection (Revankar and Sutton, 2010, Gramaje et al. 2015).
RG-2 organism.

Phaeoacremonium parasiticum colony and a phialide with a small, funnel-shaped collarette.
Morphological description:
Cultures usually slow growing, suede-like with radial furrows, initially whitish-grey becoming olivaceous-grey with age. Hyphae hyaline, later becoming brown and some becoming rough-walled. Phialides are brown, thick-walled, slender, acular to cylindrical slightly tapering towards the tip, 15-50 μm long, often proliferating, with small, funnel-shaped collarettes. Conidia, often in balls, are hyaline, thin-walled, cylindrical to sausage-shaped, 3-6 x 1-2 μm, later inflating. Maximum growth temperature 40C.
Molecular identification:
ITS and β-tubulin sequencing (Mostert et al. 2006, Gramaje et al. 2015).
Key features:
The identification of the different Phaeoacremonium species can be done by combining cultural, morphological and sequence data (Mostert et al. 2006, Gramaje et al. 2015).
| Antifungal susceptibility: Phaeoacremonium parasiticum (Badali et al. 2015, Australian national data); MIC µg/mL. | ||||||||||||
|---|---|---|---|---|---|---|---|---|---|---|---|---|
| No | ≤0.03 | 0.06 | 0.125 | 0.25 | 0.5 | 1 | 2 | 4 | 8 | 16 | ≥32 | |
| AmB | 30 | 1 | 3 | 9 | 10 | 6 | 1 | |||||
| ISAV | 21 | 3 | 6 | 7 | 5 | |||||||
| VORI | 27 | 3 | 2 | 9 | 12 | 1 | ||||||
| POSA | 25 | 6 | 10 | 8 | 1 | |||||||
| ITRA | 30 | 1 | 1 | 4 | 2 | 22 | ||||||
References
- Badali, H., Khodavaisy, S., Fakhim, H., et al. (2015) In vitro susceptibility profiles of eight antifungal drugs against clinical and environmental strains of Phaeoacremonium. Antimicrobial Agents and Chemotherapy, 59, 7818-7822
- de Hoog, G.S., Guarro, J., Gene, J., et al. (2015) Atlas of Clinical Fungi (Version 4.1.2). Centraalbureau voor Schimmelcultures, Utrecht, The Netherlands.
- Gramaje, D., Mostert L., Groenewald J.Z., Crous P.W. (2015) Phaeoacremonium: from esca disease to phaeohyphomycosis. Fungal Biology, 119, 759-783.
- Kidd, S., Halliday, C., Ellis, D. (2023) Descriptions of Medical Fungi (4th edition). CABI.
- Mostert, L., Groenewald, J.Z., Summerbell, R.C., et al. (2005) Species of Phaeoacremonium associated with infections in humans and environmental reservoirs in infected woody plants. Journal of Clinical Microbiology, 43, 1752-1767.
- Mostert, L., Groenewald, J.Z., Summerbell, R.C., et al. (2006) Taxonomy and pathology of Togninia(Diaporthales) and its Phaeoacremonium anamorphs. Studies in Mycology, 54, 1-115.
- Revankar, S.G. and Sutton, D.A. (2010) Melanized fungi in human disease. Clinical Microbiology Reviews, 23, 884-928.
